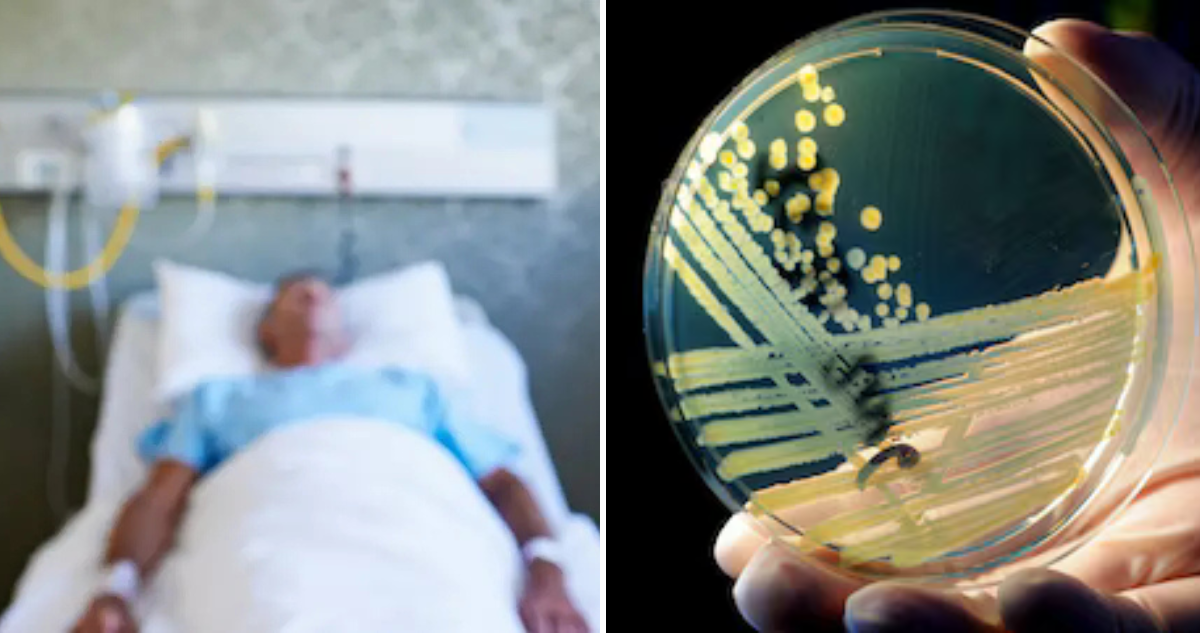
Bacterias resistentes a antibióticos

Las infecciones por bacterias altamente resistentes a los antibióticos, conocidas como NDM-CRE, aumentaron de forma preocupante en Estados Unidos, advirtieron esta semana los Centros para el Control y la Prevención de Enfermedades.
La agencia federal subrayó que estas bacterias son un grupo de gérmenes intestinales que han desarrollado resistencia a algunos de los antibióticos más potentes debido a la producción de NDM, lo que las hace extremadamente difíciles de tratar y potencialmente mortales.
“Este aumento abrupto en NDM-CRE significa que enfrentamos una amenaza creciente que limita nuestra capacidad de tratar algunas de las infecciones bacterianas más graves”, afirmó en un comunicado Danielle Rankinla, epidemióloga de la División de promoción de la calidad de la atención de los CDC.
Las afecciones por NDM-CRE incluyen neumonía, infecciones en el torrente sanguíneo, urinarias y de heridas.
Su detección es un desafío, ya que muchos laboratorios clínicos carecen de la capacidad para identificar estas bacterias rápidamente, algo que puede retrasar el tratamiento y aumentar el riesgo de propagación dentro de hospitales y hacia la comunidad.
“Seleccionar el tratamiento correcto nunca ha sido más complicado, por lo que es vital que los profesionales de la salud tengan acceso a pruebas que les ayuden a elegir terapias dirigidas adecuadas”, subrayó Rankin.
Bacterias resistentes a antibióticos
Los CDC señalaron que la propagación de NDM-CRE podría estar vinculada a fallas en el control de infecciones, como higiene de manos insuficiente o limpieza inadecuada, así como pruebas limitadas, que dificultan la detección temprana.
En 2020, las infecciones por CRE, el grupo al que pertenece NDM-CRE, fueron alrededor de 12.700 casos y causaron 1.100 muertes en Estados Unidos, constata un informe especial de los CDC sobre el impacto de la covid-19 en la resistencia antimicrobiana.
Un estudio publicado por la revista científica Annals of Internal Medicine reveló que entre 2019 y 2023 las infecciones por NDM-CRE aumentaron más de un 460 % en el país.
Las NDM-CRE son bacterias del grupo Enterobacterales (como E. coli o Klebsiella) que se han vuelto resistentes a los antibióticos carbapenémicos, considerados de último recurso, gracias a la enzima NDM (New Delhi metallo-beta-lactamasa) que les permite inactivar numerosos antibióticos y las convierte en una amenaza grave para la salud pública.
Los CDC recomendaron a los profesionales de la salud realizar pruebas inmediatas para identificar el tipo de carbapenemasa presente, la enzima que permite a estas bacterias destruir los antibióticos carbapenémicos; además de seleccionar los antibióticos con cuidado según el mecanismo de resistencia y fortalecer las medidas de prevención.







 Enviando corrección, espere un momento...
Enviando corrección, espere un momento...